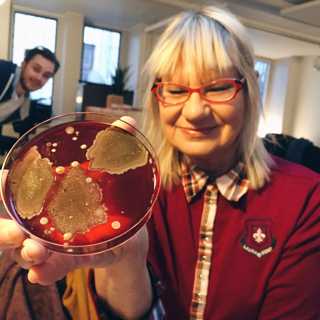
Styrkors i taket!

I skuggan av mörkret
Släck lyset och följ med P3 Spel in i mörkret! Vad betyder mörker för spelen? Hur svårt ska det vara att ställa in TV:ns brightness-reglage? Och varför vill vissa spelskapare se oss gråta? Lyssna på alla avsnitt i Sveriges Radio Play. När ljuset försvinner i skräcksspel som Silent Hill blir vet man att det vankas kalla kårar, men för för Solid Snake på infiltrationsuppdrag erbjuder nattens mörker en skyddande täckmantel. Susanne Möller, Tobias Norström och Victor Leijonhufvud utgör veckans P3 Spel-panel och de snackar om när spelmörkret är som bäst.Vi hör spelskaparen Thomas Grip som i Amnesia och Soma har skrämt skiten ur gamers med hjälp av just mörker, och Marek Ziemak som med This War of Mine: The Little Ones skildrar det emotionella mörkret i de civilas mödosamma kamp för överlevnad i en stad under belägring. Det delas ut betyg till Bloodborne-expansionen The Old Hunters och vi hajpar loss rejält när blickarna riktas mot årets mest efterlängtade spelsläpp. Det blir dessutom en krönika med Jimmy Håkansson som bland annat tänker på hur en viss rörmokare låter.Allt om spelens mörker i P3 Spel med Angelica Norgren lördag 18.03 i P3.
16 Jan 20161h 11min

Repris bonanza!
I veckans P3 Spel bjuds det på två gamla godingar! P3 Spel återhämtar sig från Årets Spel-utmärkelser och julgodissvullande med en reprisvecka som innehåller två favoritteman från året som gått! Lyssna på alla avsnitt i Sveriges Radio Play. Först ut blir det ösregn i Hyrule, dimma i Silent Hill och strålande solsken i Svampriket. P3 Spel reder ut vad väderleken betyder för spelupplevelsen och bjuder på episka väderögonblick. Sedan hör vi delar av lurendrejeriprogrammet då Susanne Möller, Victor Leijonhufvud och Tobias Norström dissade vilseledande reklam och hyllade smarta plottwistar. Hur lättlurade är vi gejmers egentligen? Du hör P3 Spel med Angelica Norgren lördag 18.03 i P3. Nästa vecka är vi tillbaka med ett sprillans nytt program och då spanar vi in vad spelåret 2016 kommer att bjuda på!
9 Jan 20161h 9min

P3 Spelgalan 2015
P3 Spel ser tillbaka på spelåret 2015 som bjöd på episka bossfighter, blomsterplockning, robotuppror och skrattretande buggar. Årets Spel ska koras i den första P3 Spel-galan någonsin! Lyssna på alla avsnitt i Sveriges Radio Play. Ta på dig din glittrigaste partystass - veckans P3 Spel blir ett riktigt galaprogram! Vi minns det bästa och sämsta från spelåret som gått och delar ut pris i kategorier som Årets Buggfest, Årets Tankeställare och Årets Det-Hade-Räckt-Med-Hälften. Spelakademien som står bakom de hedersvärda utmärelserna består av Susanne Möller, Victor Leijonhufvud och Tobias Norström. Det blir dessutom en krönika med Kerstin Alex och ett läskigt gästspel från Creepypodden med Jack Werner. Vilket spel kniper priset för Årets Identitetskris? Det hör du i P3 Spel med Angelica Norgren, lördag 18.03 i P3.
2 Jan 20161h 6min

Angelicas ljudklappar
P3 Spel-gänget mellandagsmyser och minns favoritögonblick från P3 Spel-året 2015, som bjudit på guldklimpar i form av Tokyo-äventyr, episka tävlingar, Kojima-spekulationer och livade uppläxningar. Lyssna på alla avsnitt i Sveriges Radio Play. Angelica Norgren har bjudit hem Tobias Norström, Susanne Möller och Victor Leijonhufvud på glöggfika och passar på att sammanfatta radioårets bästa (och sämsta) stunder. Det delas ut utmärkelser i kategorier så som Årets Ögonöppnare, Årets Recension och Årets Mörker. Det blir dessutom ett helt gäng med speltips för dig som är ledig har lite extra speltid till övers, samt en krönika med Michael Gill som tar med oss på sitt livs spelresa. Du hör P3 Spel med Angelica Norgren, lördag 18.03 i P3.
26 Dec 20151h 4min

Skrattfest i P3 Spel
Skrattar du åt Duke Nukems oneliners? Eller är det snubblande getter och trasig fysik som får dig att dra på smilbanden? Vad som får P3 Spel att garva hör du i veckans avsnitt som handlar om humor! Lyssna på alla avsnitt i Sveriges Radio Play. Komikern Victor Linnér (ni vet, från Morgonpasset i P3!) kommer på besök och pratar om humorn som verktyg i spel tillsammans med P3 Spel-panelen som består av Susanne Möller, Tobias Norström och Victor Leijonhufvud. Var det bättre förr när äventyrsspel som Monkey Island bjöd på finurliga skämt eller är det nu vi har som roligast när fjärde väggen rivs humorn blir politisk? Spelskaparen William Pugh som ligger bakom bland annat The Stanley Parable snackar om kruxet med att få gejmers att garva och vikten av en rolig berättarröst. Det blir dessutom recension av explosionsfesten Just Cause 3 och intryck från Overwatch-betan och Divinity: Original Sin samt en krönika med Effie Karabuda. Du hör P3 Spel med Angelica Norgren, lördag 18.03 i P3.P.s. Sista P3 Spel-programmet innan julafton och vi bjussar givetvis på några rim, det bästa från Susanne Möller:Du, min son, en skapandets gåva har att vänta en lek för alla dom som inte är valhänta. Rita, bygg och lek för allt vad du orkar, gör fel, gör om och låt dina tårar torkar. En mustaschprydd ikon håller dig i handen när du på ökenbanan strör ut sanden. Nu till några viktiga ordningens ord, så vi slipper onödiga bråk vid vårt matbord. Ty denna klapp kommer med ett litet förbehåll: Du ska bygga tillsammans med någon som har lite mindre koll.
12 Dec 20151h 17min

Specialpodd om Dota 2: Att bygga det perfekta laget, storyn om Icefrog och "Var är brudarna?"
Alliance har en ny laguppställning - det måste vi snacka om! I säsongens sista specialpodd om Dota 2 undrar vi dessutom vem Icefrog egentligen är och varför vi ser så få brudar på proffscenen. Lyssna på alla avsnitt i Sveriges Radio Play. Joakim "Akke" Akterhall berättar om tankarna bakom spelarbytet i Alliance nu när EGM är tillbaka i familjen. Det blir dessutom längtan efter Warcraft 4, tips på hur man överlever som fattig support och de bästa sätten att ragga nya spelkamrater samt en djupdykning i storyn bakom spelutvecklaren Icefrog. Det visar sig att Akke vet mer än många andra om den mystiska Dota 2-legenden...Säsongens sista avsnitt av P3 Spel: Specialpodd om Dota 2 hittar du här på hemsidan och i P3 Spels poddflöde.
12 Dec 201529min
Styrkors i taket!
Full kontroll i veckans P3 Spel! Vi klämmer på handkontrollsnyheter, provar att styra spel med ögonen och får svar på den äckliga frågan: hur snuskiga är våra spelkontroller? Lyssna på alla avsnitt i Sveriges Radio Play. En unken doft sprider sig i studion när Marie-Louise Danielsson Tham packar upp våra bakterieodlingar. Hur mycket äckligheter ryms mellan panelens knappar och styrspakar? Tobias Norström, Susanne Möller och Victor Leijonhufvud blåser liv i bortglömda handkontroller och vi snackar om framtidsutsikterna för våra styrdon. Är dags att släppa handkontrollen? Vi får besök i studion av teknikföretaget Tobii som låter oss prova på ett nytt sätt att styra spel, nämligen med blicken.I recensionerna delas det ut betyg till Call of Duty: Black Ops 3 och Yoshi’s Wooly World. För dig som inte fattat grejen med Warcraft bjuder vi på en Sen till Partyt och det blir dessutom en krönika med Jimmy Håkansson. Du hör P3 Spel med Angelica Norgren lördag, 18.03 i P3.
5 Dec 20151h 9min

Specialpodd om Dota 2: Evany Chang, Blewd och S4
Smockfullt med Dota 2-profiler! Den här veckan snackar vi speltatueringar, hur man boostar lagmoralen och tar reda på vad managern till världens just nu bästa Dota 2-lag sysslar med. Lyssna på alla avsnitt i Sveriges Radio Play. Angelica Norgren och Joakim "Akke" Akterhall bjuder på inte mindre än tre intervjuer från Dreamhack i veckans avsnitt. Hör Evany Chang berätta om livet som manager för OG, få inblick i hur det var bakom kulisserna på TI5 med Mats "Blewd" Nilsson och bli en bättre spelare med proffset Gustav "s4" Magnusson som alltid verkar kunna få lagkamraterna i Alliance på bra humör.Veckans avsnitt av P3 Spel: Specialpodd om Dota 2 släpps onsdag 15.00 här på hemsidan och i P3 Spels poddflöde.
2 Dec 201527min






















